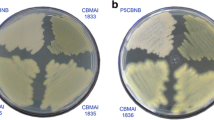

Abstract
Biodegradation of endosulfan (α and β) and pendimethalin by Bacillus safensis strain FO-36bT, Bacillus subtilis subsp. inaquosorum strain KCTC 13429T and Bacillus cereus strain ATCC14579T isolated from pesticides-polluted soil was studied in mineral salt medium. Endosulfan and pendimethalin were incubated with the three bacterial strains with samples drawn at various intervals for GC analysis. Representative samples were subject to GC–MS analysis. The loss in the initial concentrations, 0.663 mM (α endosulfan), 0.319 mM (β endosulfan) and 1.423 mM (pendimethalin), was monitored and used to compute the half-lives following biphasic model. Removal percentage of endosulfan and pendimethalin in the media inoculated with the bacterial strains ranged from 24 to 95% (α endosulfan), 21–91% (β endosulfan) and 51–97% (pendimethalin), respectively. Despite the significant decrease in starting material in B. safensis cultures, no metabolites were detected, whereas two major metabolites of endosulfan, 1,2,3,4,7,7-hexachloro-5,6-dihydroxybicyclo{2.2.1}-2-heptene and 1,2,3,4,7,7-hexachloro-formaldehyde-6-methylbicyclo{2.2.1}-2-heptene, were detected in the B. subtilis cultures, and one metabolite of pendimethalin metabolite; N-(1-ethylpropyl)-3-methyl-2, 6-diaminobenzine, was detected in the B. cereus culture. Generally, the result indicates the potential capability of these microorganisms in complete mineralization of endosulfan and pendimethalin. Based on half-lives, the efficiency of bacterial strains can be ordered as follows: B. subtilis > B. cereus > B. safensis for endosulfan and B. cereus > B. safensis > B. subtilis for pendimethalin.
Similar content being viewed by others
Explore related subjects
Discover the latest articles, news and stories from top researchers in related subjects.Introduction
Sudan started to use pesticides as early as the late 1940s. Irrigated cotton schemes are the major sectors using pesticides in the country. The annual consumption of pesticides in Sudan had changed over time from an average amount of 5000 Metric Ton (MT) before the 1990s to an average of 2000–3245 MT after that for many reasons; they are change in agriculture policies, drop in area allotted for cotton, adoption of integrated pest management (IPM) and other reasons [1, 2]. The poor or substandard storage facilities and management practices led huge amounts of the stored pesticides to become obsolete. According to the last inventory, the total amounts of the obsolete pesticides in Sudan was estimated at 666 tons, with about 6459 cubic meters of contaminated storage soil scattered over 43 major and minor sites in the country [3]. Currently, estimates may approach 15,000 MT including 13,000 MT of contaminated soil and 2000 MT of obsolete stocks and empty container (Plant Protection Directorate (PPD), Personal communication). Horizontal and vertical movement of contaminants was reported [4, 5]. Corroded containers release significant amounts to underneath soil. Most of the stores neighbored residential areas or surface freshwater bodies.
Endosulfan was registered in Sudan under many trade names, and its average annual import exceeded 91 tons (PPD import statistics, 2006–2010). Recent inventories indicated that this compound constitutes a major fraction of the obsolete pesticide stocks and therefore may represent a major contributor to soil contamination in hot spots.
Pendimethalin is the second main herbicide in the Sudan, which constitutes about 7% of herbicide annual import after 2, 4-D [6]. It is registered in the Sudan under 17 trade names and used in the major irrigated agricultural schemes such as Gezira, Elrahad and New Halfa. Pendimethalin was classified as persistent bioaccumulative toxicant EPA [7], highly toxic to fish and aquatic invertebrates [8], and has been classified as a possible human carcinogen EPA [9]. It disrupts the endocrine, reproductive, and immune systems and can cause neurobehavioral disorders [10].
Microorganisms play an important role in the conversion of cyclodiene insecticides in soil to nontoxic products. Endosulfan can be completely degraded in about 2 weeks to nontoxic metabolite under anaerobic conditions [11]. Microbial degradation of endosulfan was reported by Shivaramaiah and Kennedy [12]. They identified endosulfan diol as the major degradation product in an undefined mixture of microorganisms obtained from soil suspension. Siddique et al. [13] and Shetty et al. [14] reported that degradation of endosulfan occurred in culture contaminant with bacterial growth when endosulfan was used as the only source of sulfur in the culture, while no growth occurred in the absence of endosulfan [10].
In Sudan, earlier reports [1, 2, 15] argued the potential use of indigenous soil microorganisms in cleaning highly polluted soil and dump sites. The subsequent preliminary investigation indicated a promising potential of indigenous microorganism in the degradation of endosulfan and γ-HCH [16]. The potential of some indigenous soil microorganism in the degradation of endosulfan was further studied by Elsaid et al. [17] who found that most indigenous microorganisms are capable of degrading endosulfan. Degradation rates can be enhanced by many activators [18], and wild types are more potent than mutant (tolerant) strain [19]. The degradation of pendimethalin by three bacterial strains (Pseudomonas aeruginosa, Bacillus mycoides and Bacillus cereus) isolated from pesticides-contaminated soil was studied by Shaer et al. [20] who reported that the Pseudomonas aeruginosa is capable of complete mineralization of this compound. However, the previous studies either used unidentified mixed cultures or relied on biochemically identified microorganisms and nonused molecular tools in identification. Recently in a parallel work, molecular tools were used to characterize the isolated strains which showed high efficiency in degrading three organophosphorous insecticides [21]. Validation of the above results requires further testing with other chemical groups. Therefore, the objective of this study is to confirm the capability of these isolates to degrade frequently reported pesticidal contaminants from other chemical groups. Based on this, endosulfan and pendimethalin, being frequently reported contaminants from a different chemical group, were selected. Positive results will encourage further work on these isolates as potential agents for the subsequent bioremediation studies.
Materials and methods
Chemicals and reagents
Analytical standards of the endosulfan (96.5%) and pendimethalin (99.9%) were obtained from the Agricultural Research Corporation, Sudan. Acetone (99.8%), n-hexane (99.8%) and methanol (99.8%) were obtained from Fisher Company, UK. Sodium chloride (99.5%) and anhydrous sodium sulfate (99%) were purchased from Lab Line Company, Sudan.
Isolation and identification of microorganisms from pesticides-polluted soils
Surface soil samples were randomly collected from pesticides-polluted storage soil in Hasahesa (Gezira irrigation scheme), using a soil auger of 10 cm length and 5 cm diameter. Five augers were taken and mixed thoroughly to make a composite sample (1 kg). The collected sample was placed in a paper bag, labeled and immediately transported to the Microbiology Laboratory, University of Khartoum.
One gram of soil sample was weighed and placed in a sterilized test tube containing ten mL distilled water. The contents were well shaken to give the first dilution (10−1). The other five dilutions (10−2, 10−3, 10−4, 10−5, and 10−6) of each soil sample were prepared by serial dilution from the respective preceding concentration. From each of the six serial dilutions of the soil, one mL was transferred to the nutrient agar surfaces in the plate. The plates were then incubated in an incubator at 37 °C for 48 h.
Purification and identification of microorganisms
Predominant microorganisms from morphologically different colony types were selected from plate count agar. The isolates were purified by subculturing in nitrate agar. Typical colonies were then streaked onto sterile nutrient agar plates for propagation. The plates were incubated at 37 °C for 24 h. The representative colonies of various microorganisms were subcultured in nutrient agar media (on a slope), and then, the cultures were kept in the refrigerator at 4 °C until used for the further test. The identification of purified isolates was carried out according to Cowan and Steel [22]. The bacterial isolates were first identified by the biochemical test. The identified isolates have been reconfirmed by molecular biotechnology.
Extraction of DNA and PCR amplification and sequencing of 16S rDNA
Extraction of DNAs was carried out at Macrogen Ltd., Korea. PCR amplification and sequencing of the 16S rRNA gene were performed. The 16S rRNA genes were PCR-amplified from the genomic DNA using the bacterial Macrogen universal primer set of 27F 5′ (AGA GTT TGA TCM TGG CTC AG) 3′ and 1492R 5′ (TAC GGY TAC CTT GTT ACG ACT T) 3′. Analysis of nucleotide sequences, confirmation of microorganism and homogenic data using rRNA database (NCBI) after amplification of bacteria RNA ribosomal were done. All sequences generated in this study have been deposited in GenBank with accession numbers in the Entrez retrieval system (http://www.ncbi.nlm.nih.gov/sites/entrez). The determined sequences of 16S rRNA gene were analyzed in the EZBIOCLOUD database (http://www.ezbiocloud.net/eztaxon). Sequencing alignment was performed using the CLUSTALW program [23]; the sequences were verified and edited using BioEdit 7.2.5.
Phylogenetic analysis
The phylogenetic trees were constructed using the neighbor-joining algorithm with Mega 6.0 as described previously [21]. The strengths of internal branches of resulting trees were statistically evaluated by bootstrap analysis with 1000 bootstrap replications. The results of 16S rRNA sequence analysis used to reconfirm the identification of bacterial isolates recognized the isolated strains as follows: strain1, Bacillus cereus strain ATCC14579T with accession AE016877, strain2, Bacillus subtilis subsp. inaquosorum strain KCTC 13429T with accession AMXN01000021 and strain3, Bacillus safensis strain FO-36bT with accession ASJD01000027. The identified bacterial strains were subcultured in meat peptone agar (MPA) for 24 h prior to their use in biodegradation studies in mineral salt medium (MSM) (3% carbon content).
Preparation of media
MPA: The MPA was prepared by adding 5 g of meat extract, 7.5 g of peptone, 5 g of NaCl and 20 g of agar to 1.0 L of distilled water according to the methods of Tepper et al. [24]. The pH value of the medium was 7.5.
MSM: The MSM was prepared following the method described by Tepper et al. (199). 1 g of K2HPO4, 0.5 g of MgSO4·7H2O, 0.5 g of NaCl, 0.001 g of FeSO4·7H2O, 0.01 g of MnSO4.4H2O, 0.05 g of CaCO3 were added to a conical flask (1500 ml), and then, the suspension was topped up to 1 L by adding distilled water. The pH value of the medium was 6. The media were autoclaved for 20 min at 121 °C and then allowed to cool at room temperature and kept in a refrigerator at 4 °C until used.
Preparation of the microbial inocula
Three quantities of MPA, 200 ml each, were taken, and each was placed separately in 250-ml Erlenmeyer flask. Each flask was inoculated with one bacterial isolate using sterilized loops. Inoculated flasks were then closed with sterilized cotton and placed in a shaking incubator (thermostatic cabinet) at 25 °C for 24 h for use in biodegradation experiment.
Microbial degradation of endosulfan and pendimethalin in mineral salt medium
The aim of this experiment was to evaluate the capability of the isolated and identified bacterial isolates in the degradation endosulfan and pendimethalin in carbon-free media (CFM).
A total of 120 clean test tubes were sterilized in an oven for 3 h at 180 °C. Ten ml of MSM was taken from the stock flasks into each test tube. One ml of inoculum was added to each test tube. The cultured test tubes were incubated at 25 °C with 0.663 mM α endosulfan, 0.319 mM β endosulfan and 1.421 mM pendimethalin for 0, 3, 7, 14 and 30 days. The experimental units were arranged in a completely randomized design (CRD) with three replicates. Control sets without bacterial inoculum were incubated under the same conditions. All treatments were applied on the recovery test. The recovery sets were immediately extracted and kept in the refrigerator for the gas chromatographic (GC) analysis.
Extraction of endosulfan and pendimethalin from the culture
Treated cultures were centrifuged at 800 rpm for 10 min to separate the microorganisms from the media. The supernatant was removed by careful decanting and placed in a 100-ml separating funnel. Ten ml of n-hexane: acetone mixture (3:1, respectively) was added followed by five ml of saturated sodium chloride solution and one ml of methanol. The contents were vigorously shaken for 5 min, while the cork was frequently opened to relief the pressure and then allowed standing for 1 min until separation of layers. The n-hexane layer was collected in a clean test tube, and the aqueous layer was re-extracted twice with 10 ml n-hexane. The n-hexane fractions were recombined in a clean test tube, and water was removed by passing through anhydrous sodium sulfate on filter paper. The solvent was stripped off by rotary evaporator at 68 °C till dryness and the residues were re-constituted in 10 ml n-hexane and stored in the refrigerator at 4 °C for GC analysis.
Gas chromatographic analysis
A Shimadzu GC-2010 Plus equipped with flame ionization detector (FID) and a DB-5 fused silica capillary column of 30 m long with a 0.25 μm i.d. was used for analysis of the extracts. The stationary phase (0.25 mm thickness) was 5% phenyl, methylpolysiloxane. The detector and injector temperatures were 300 and 280 °C, respectively. Nitrogen was used as a carrier gas at a flow rate of 4.23 ml min−1. The oven temperature was programmed as follows: initial temperature was 100 °C, held for 2 min then increased at 16 °C min−1 to 180 °C, held for 3 min, and subsequently increased by 16 °C min−1 to a final temperature of 240 °C, at which it was held for 3 min. Flow rates of the makeup gas (helium), hydrogen and air were 30, 40 and 400 ml min−1, respectively. Analyses of samples were done by duplicate injection of two microliters. Three concentrations of analytical standard 0.663, 0.331 and 0.165 mM for α endosulfan; 0.319, 0.159 and 0.079 mM for β endosulfan; and 1.421, 0.71 and 0.14 mM for pendimethalin were injected under the same conditions, and responses were used for the construction of the standard curve. Reanalysis of the analytical standard was repeated every morning to check for the performance of the machine. The septum was changed when necessary. The limit of detection (LOD) of endosulfan isomers (α and β) and pendimethalin was 0.00035, 0.0113 and 0.0012 mM, respectively. The recovery of the method ranged from 91 to 99% for endosulfan and 83 to 96% for pendimethalin.
Gas chromatography with mass spectrometric (GC–Ms) analysis
Three representative samples were reanalyzed using a Shimadzu GC–Ms Qp2010 system with an AOC-5000 autosampler. The gas chromatography was fitted with a Rtx5-Ms capillary column, 30 m × 0.25 mm i.d., 0.25 µm film thickness, sourced from Restek. Helium (purity > 99.999%) was used as a carrier gas at a flow rate of 1.24 ml min−1. The splitless injection temperature was 200 °C. The oven temperature was programmed from an initial temperature of 100 °C held for 2 min, then increased by 16 °C min−1 to 180 °C, held for 6 min, and finally increased by 16 °C min−1 to 240 °C, at which it was held for 3 min. The mass spectrometer was operated with an electron impact (E I) source in the scan mode. The electron energy was 70 eV, and the interface temperature was maintained at 200 ◦C as well as the ion source. The solvent delay was set to 2 min.
Statistical analysis
The data were analyzed using the analysis of variance (ANOVA). A probability of 0.05 or less was considered significant (SAS 2004 and MINITAB software version 13.20). Data are expressed as mean ± SD (standard deviation) from at least three independent trials. The rate constant of pesticide degradation was calculated by exponential analysis (Microsoft Excel 2010). A biphasic model was assumed to characterize the loss of endosulfan (alpha and beta) and pendimethalin from the media inoculated with different strains of bacteria. The calculations are done according to the following equation:
where R = the amount of endosulfan at t days, A 0 and B 0 are a concentration of endosulfan (alpha and beta) and pendimethalin at t = 0, α and β are the disappearance rate constant for first- and second-phase models, respectively. The half-life of exponential decay is calculated according to Eq. 2.
Results
Biodegradation of endosulfan and pendimethalin in mineral salt medium (MSM)
Results in Fig. 1 indicated the phylogenetic relationships between the type strains of the type species of Bacillus and isolated strains based on the analysis of partial 16S rDNA sequences. Numbers above and below branches indicate bootstrap values from neighbor-joining analysis [21].
The results indicated that all the three indigenous strains of bacteria are capable of degrading endosulfan and pendimethalin in a MSM (Table 1). The concentration of endosulfan and pendimethalin decreased gradually with the increases in the incubation periods. Since this media is very poor in carbon (almost free) therefore those microorganisms may be forced to utilize the pesticide as a major source of carbon. Generally, disappearance rates of alpha endosulfan were low from day 14 on in B. cereus strain ATCC14579T and B. subtilis subsp. inaquosorum strain KCTC 13429T cultures while those of beta endosulfan were low from day 3 on. However, in Bacillus safensis strain FO-36bT cultures the rate was low from day 7 on for the two endosulfan isomers. On the other hand, the disappearance rates of pendimethalin were low from day 7 on in the cultures of the two Bacillus strains (B. cereus strain ATCC14579T and B. subtilis subsp. inaquosorum strain KCTC 13429T), whereas in B. safensis strain FO-36bT cultures the disappearance rates of pendimethalin were low from day 3 on (Table 1).
The percentage removal of alpha and beta endosulfan from the media inoculated with B. safensis strain FO-36bT ranged from 25 to 62 and 21 to 64, respectively, whereas in pendimethalin it ranges from 69 to 91 (Figs. 2, 3 and 4). On the other hand, the respective removal of alpha and beta endosulfan by B. subtilis subsp. inaquosorum strain KCTC 13429T ranged from 91 to 95 and 91 to 92, respectively, whereas the removal of pendimethalin from the media ranged from 51 to 91. The respective removal values for B. cereus strain ATCC14579T were 56–70 for alpha endosulfan, 61–70 for beta endosulfan and 50–89 for pendimethalin (Fig. 2, 3 and 4). The recovery of the method ranged from 91 to 99% for endosulfan and 83 to 96% for pendimethalin.
Biodegradation kinetics
The data in Table 2 indicated that there was a faster rate of disappearance in the first phase than the second of all pesticides. This is clearly reflected in the half-life values obtained. The half-lives (t1/2α) of the first phase of α endosulfan were estimated at 7.32, 0.85 and 2.54 days, while the corresponding values for the second phase (t1/2β) were 21.32, 1.82 and 5.43 days in media inoculated with B. safensis strain FO-36bT, B. subtilis subsp. inaquosorum strain KCTC 13429T and B. cereus strain ATCC14579T, respectively. On the other hand, the half-lives (t1/2α) of the first phase of β endosulfan were estimated at 8.62, 0.87, and 2.18 days, whereas the respective values for the second phase (t1/2β) were 37.65, 2.02 and 5.04 days. However, for pendimethalin the half-lives (t1/2α) of the first phase were estimated at 2.12, 1.60 and 2.54 days, while the corresponding values for the second phase (t1/2β) were 5.26, 3.55, and 5.79 days in media inoculated with B. safensis strain FO-36bT , B. cereus strain ATCC14579T, B. subtilis subsp. inaquosorum strain KCTC 13429T, respectively.
The first-phase degradation constants for alpha and beta endosulfan in media incubated with B. safensis strain FO-36bT , B. cereus strain ATCC14579T, B. subtilis subsp. inaquosorum strain KCTC 13429T were 0.09, 0.27, and 0.82 day−1; 0.08, 0.32, and 0.79 day−1, respectively. The corresponding values for the second phase were 0.03, 0.13, and 0.38 day−1; 0.03, 0.14, and 0.34 day−1 (Table 2). On the other hand the first-phase degradation constants of pendimethalin in media incubated with B. safensis strain FO-36bT , B. cereus strain ATCC14579T, B. subtilis subsp. inaquosorum strain KCTC 13429T were 0.33, 0.43, and 0.27 day−1, respectively. The corresponding values for the second phase were 0.13, 0.2, and 0.12 day−1 (Table 2). The results in Table 3 indicate that the decay constant decreases with increasing incubation period with the three strains of bacteria.
Biodegradation products
Despite the significant decrease in starting material in B. safensis strain FO-36bT cultures, no metabolites were detected, whereas two major metabolites of endosulfan, 1,2,3,4,7,7-hexachloro-5,6-dihydroxybicyclo{2.2.1}-2-heptene and 1,2,3,4,7,7-hexachloro-formaldehyde-6-methylbicyclo{2.2.1}-2-heptene, were detected in B. subtilis subsp. inaquosorum strain KCTC 13429T culture. On the other hand, one metabolite of pendimethalin, N-(1-ethylpropyl)-3-methyl-2, 6-diaminobenzine, was detected in B. cereus strain ATCC14579T culture.
Discussion
Biodegradation is a sustainable cost-effective and practical technique for the degradation of pesticides in the polluted environment. However, this approach may have some disadvantages, such as the formation of undesirable degradation products that may require desorption or further treatment, but its benefits outweigh this. Biological removal of chemical pollutants becomes the method of choice since microorganisms can use a variety of xenobiotic compounds including pesticides for their growth and consequently detoxify or ultimately mineralize them. In the present study, the pesticide-degrading bacteria were identified by biochemical tests according to the method of Cowan and Steel [22], and the identification was reconfirmed by molecular biotechnology.
The results indicated that all the identified strains of bacteria (B. safensis strain FO-36bT, B. subtilis subsp. inaquosorum strain KCTC 13429T and B. cereus strain ATCC14579T) are capable of degrading alpha and beta endosulfan as well as pendimethalin in the mineral salt medium. Reduction in the levels of pesticides was substantial and increased with the increase in the length of incubation period. The removal of endosulfan and pendimethalin from the media inoculated with B. subtilis subsp. inaquosorum strain KCTC 13429T exceeds 90%. The removal of endosulfan and pendimethalin from media exceeded 70% by the other two organisms (B. safensis strain FO-36bT and B. cereus strain ATCC14579T). Since the medium used is poor in carbon, therefore, these microorganisms may have utilized the pesticide as a major carbon source as argued by [20, 21, 27].
Endosulfan and pendimethalin were reported to be degraded in soil by many microorganisms including organic and inorganic nitrogen bacteria, Staphylococcus sp., Bacillus circulans, Klebsiella oxytoca [17, 25, 26], Bacillus megaterium, Pseudomonas sp, Pyricularia sp, Rhizobium sp, Trichoderma viride aeruginosa, Bacillus mycoides, Bacillus cereus and Agrobacterium tumefaciens [27,28,29,30]. Also, they include fungi, actinomycetes, Anabaena sp. Trametes versicolor, Pleurotus ostreatus and Gloeophyllum trabeum, Fusarium oxysporum, Paecilomyces variotii and Rhizocotonia bataticola [17, 31,32,33]. Bacillus sp, Bacillus cereus, Bacillus mycoides, Bacillus safensis strain FO-36bT , Bacillus subtilis sub sp. inaquosorum strain KCTC13429T and Bacillus cereus strain ATCC14579T, Pseudomonas aeruginosa, Micrococcus spp, and Proteus spp were reported as degraders of many organic compounds such as pesticides and petroleum products [8, 20, 21, 27, 34, 35].
The current study agrees with the argument of Abdelbagi et al. [1, 2] that indigenous soil microorganisms could be used to reduce the level of contamination by pesticides in highly polluted storage soils in Sudan. Their suggestion is in line with that of El Zorgani [28] who found that although large quantities of DDT and other pesticides have been applied to crops in Gezira scheme, Sudan, the soil level was relatively low, which indicate the existence of a possible biological and physical degradation processes in these soils. This argument was later confirmed by Ali [16], Elsaid et al. [17, 18, 36], Shaer et al. [20], Abdurruhman et al. [27], and Ishag et al. [21] who demonstrated the high efficiency of indigenous soil microorganisms, especially those isolated from pesticide-polluted soils, in degrading pesticidal pollutants present in storage soils and other hot spots. Elsaid and Abdelbagi [19] also reported that their isolated indigenous strains (bacteria and fungi) can tolerate up to 1000 ppm of endosulfan without significant reduction in their degradation capability. Various types of synthetic and natural fertilizers enhanced their degradation rates [18]. B. cereus has been reported to degrade malathion and malaxon in soil slurry system [37]. Thangadurai and Suresh [30] reported that the Agrobacterium tumefaciens isolated from contaminated soil have the ability to degrade α and β isomers of endosulfan with equal efficiencies without accumulation of known toxic intermediates or end products. Shivaramaiah and Kennedy [12] found that about 50% of mixture endosulfan isomers disappeared from soil bacterium within 3 days concomitant with the formation of endosulfan metabolites and increased in bacterial biomass. Rapid decreases of the concentrations of endosulfan and endosulfan sulfate with simultaneous increases in the biomass were reported in the culture of Klebsiella oxytoca KE-8 [25].
Generally, the disappearance rates by the three strains of bacteria followed a biphasic model with the initial faster rate in the first phase followed by a second phase of slower disappearance. This phenomenon of biphasic disappearance in soil is common in many pesticides [20, 21, 27, 38]. The relative importance of the phases depends upon the availability of the pollutants, hydrophobicity, and affinity for organic matter [39].
Despite the significant decreases in the starting material of endosulfan isomers (alpha and beta) and pendimethalin, no metabolites were detected in B. safensis strain FO-36bT culture. Similar results were mentioned by Awasthi et al. [40] who reported aerobic degradation of endosulfan by bacteria co-culture without formation of any metabolites. In a bioremediation study, Jesitha et al. [41] found that α and β endosulfan had been completely degraded by Pseudomonas fluorescens within 18 days without the detection of any intermediate metabolites. The absence of detectable levels of breakdown products on pesticides biodegradation studies involving bacteria and fungi was reported by many authors [38]. Two major metabolites of endosulfan, 1,2,3,4,7,7-hexachloro-5,6-dihydroxybicyclo{2.2.1}-2-heptene and 1,2,3,4,7,7-hexachloro-formaldehyde-6-methylbicyclo{2.2.1}-2-heptene, were detected after biodegradation by B. subtilis subsp. inaquosorum strain KCTC 13429T culture. These metabolites can be formed by oxidative and hydrolytic pathways [42]. Katayama and Matsumura [43] also showed that the culture of Trichoderma harzianum was capable of producing endosulfan diol as a principal metabolite. They suggested that a hydrolytic enzyme sulfatase is responsible for the indirect formation of endosulfan diol by hydrolysis of endosulfan sulfate. Sutherland et al. [44] reported that the hydrolysis pathway of endosulfan beta could yield monoaldehyde and hydroxylether, whereas degrading the alpha isomer could give endosulfan sulfate. Miles and May [45] have proposed pathway, wherein endosulfan is converted into endosulfan sulfate as well as endosulfan diol, endosulfan hydroxylether, and endosulfan lactone. The formation of these metabolites has also been confirmed by Katayama and Matsumura [43]; Kullman and Matsumura [42] while working with fungi. One metabolite of pendimethalin (N-(1-ethylpropyl)-3-methyl-2, 6-diaminobenzine) was detected in the culture of B. cereus strain ATCC14579T. The detected pendimethalin metabolite could be formed by reduction of NO2 groups into NH2 and demethylation of one of the methyl groups. The reduction of NO2 groups has been reported by Singh and Kulshrestha [32], Megadi et al. [8, 34] and Shaer et al. [20]. Singh and Kulshrestha [32] found that Bacillus sp. strain MS202 initially reduced the NO2 group into NH2 under aerobic conditions. Hai-yan et al. [46] reported that a nitroreductase purified from the pendimethalin-degrading strain of Bacillus subtilis Y3 reduced the C-6 nitro group of the aromatic ring of pendimethalin, yielding 2-nitro-6-amino-N-(1-ethylpropyl)-3,4-xylidine, and also catalyze the nitroreduction of three other major varieties of dinitroaniline herbicides. Elsayed and El-Nady [47] noticed that the pendimethalin herbicides can be dissipated after 4 weeks from Pseudomonas putida (E15) culture. They also found that the growth response of P. putida increased gradually with the increase in pendimethalin dissipation rate. Megadi et al. [8, 34] reported that B. circulans could degrade pendimethalin through oxidative N-dealkylation and nitroreduction pathways. The nitro group reduction and oxidative N-dealkylation destroys of pendimethalin activity lead to its detoxification [29].
The current results indicated the great potential of indigenous microorganisms isolated from pesticide-polluted soils in degrading endosulfan (alpha and beta) and pendimethalin under conditions of the mineral salt medium. In light of the current and the previous results [2, 5, 15, 17 and 37], the use of such microorganisms in cleaning pesticides-polluted soils through bioremediation techniques is of great potential and deserve studies including the use activators and validation of the results under semi-field and field conditions.
References
Abdelbagi AO, Elmahi MA, Osman DG (2000) Chlorinated hydrocarbon insecticide residues in the Sudanese soils of limited or no pesticide use. Arab J Plant Protect 18:35–39
Abdelbagi AO, Elmahi MA, Osman DG (2003) Organochlorine insecticides residues in sudanese soils of intensive pesticide use and in surface soil of Qurashi pesticide store. UK J Agric Sci 11:59–68
Butrous (1999) Evaluation and assessment of obsolete and banned pesticides in five agricultural schemes. Report, 83–89, Sudan
Abubaker OAW (2007) Level and movement of pesticide contaminants in the dangerous area of Port Sudan Harbour and their impact on human and aquatic life. Dissertation, University of Khartoum
Babiker M (1998) Levels and movement of some pesticides in Qurashi store area. Hessahisa province, central Sudan, Dissertation, University of Khartoum
Abdelbagi AO, Mohamed AA (2006) Pesticide residues in the Sudanese environment. In: Proceedings of a national workshop on measures for import, storage, handling and use of pesticides and fertilizers. Friendship Hall, Khartoum, Sudan. Organized by the Sudanese Standards and Metrology Organization, Khartoum. Sudan. Aug 2007. pp 66–118
Environmental Protection Agency (EPA) (1999) Persistent bioaccumulative toxic (PBT) chemicals. Final Rule, Fed. Regist 64, 58666 58753
Meister RT (1992) Farm chemicals handbook ‘92. Meister Publishing Company, Willoughby
Environmental Protection Agency (1992) National study of chemical residues in fish: U.S. environmental protection agency, office of science and technology, EPA- 823-R-92-008b, v. 2, variously paged. Appendix 115
Ritter L, Solomon KR, Forget J, Stemeroff MO, Leary C (2007) Persistent organic pollutants: an assessment report on: DDT, aldrin, dieldrin, endrin, chlordane, heptachlor, hexachlorobenzene, mirex, toxaphene polychlorinated 13 biphenyls. Dioxins and furans, Prepared for The International Programme on Chemical Safety (IPCS)
Guerin TF (1999) The anaerobic degradation of endosulfan by indigenous microorganisms from low oxygen soils and sediments. Environ Pollut 106:13–21
Shivaramaiah HM, Kennedy IR (2006) Biodegradation of Endosulfan by soil bacteria. J Enviorn Sci Health B 41:895–905
Siddique T, Okeke BC, Arshad M, Frankenberger WT (2003) Enrichment and isolation of endosulfan-degrading microorganisms. JEQ 32:47–54
Shetty PK, Mitra J, Murthy NBK, Namitha KK, Sovitha KN, Raghu K (2000) Biodegradation of cyclodiene insecticide endosulfan by Mucor thermo---hyalospora MTCC 1384. Curr Sci 79:1381–1383
Elmahi MA (1996) Distribution of chlorinated hydrocarbon pesticides residues in Sudan soil. M.Sc. Dissertation, University of Khartoum
Ali TM (2005) Naturally occurring soil microorganism in qurashi pesticides store and the surrounding Gezira soil areas and their potential in degrading Endosulfan α, β and lindane. Dissertation, University of Khartoum
Elsaid OG, Abdelbagi AO, Elmustafa EA (2010) Microbial degradation of endosulfan in carbon free media and selective media. Res J Agric Biol Sci 6(3):257–562
Elsaid OG, Abdelbagi AO, Elsheikh EAE (2009) Effects of fertilizers (activators) in enhancing microbial degradation of endosulfan in soil. Res J Environ Toxicol 3(2):76–85
Elsaid OG, Abdelbagi AO (2010) Comparative biodegradation of endosulfan by mutant and their native microorganisms. Res J Agric Biol Sci 6(6):953–961
Shaer IBS, Abdelbagi AO, Elmustafa EA, Ahmed SAI, Osama GE (2013) Biodegradation of pendimethalin by three strains of bacteria isolated from pesticides polluted soils. U K J Agric Sci 21(2):233–252
Ishag ASA, Abdelbagi AO, Hammad AMA, Elmustafa EA, Osama EE, Hur J-H, Laing MD (2016) Biodegradation of chlorpyrifos, malathion, and dimethoate by three strains of bacteria isolated from pesticide-polluted soils in Sudan. J Agric Food Chem 64:8491–8498
Barrow GI, Feltham RKA (2003) Cowan, and steel’s manual for identification of medical bacteria, 3rd edn. Press Syndicate of the University of Cambridge, Cambridge, p 317
Thompson R, Marcelino A, Polz F (2002) Heteroduplexes in mixed-template amplifications: formation, consequence and elimination by ‘reconditioning PCR’. Nucleic Acids Res 30(9):2083–2088
Tepper EZ, Shilnikova VK, pereverzeva GI (1994) A manual of Microbiology (In Russian), 4th Edition, kolas Publishers Moscow. 170 p
Gi-Seok K, Ho-Yong S, Kee-Sun S (2005) Biodegradation of the organochlorine insecticide, endosulfan, and the toxic metabolite, endosulfan sulfate, by Klebsiella oxytoca KE-8. Appl Microbiol Biotechnol 67:845–850
Mathava K, Ligy P (2006) Endosulfan mineralization by bacterial isolates and possible degradation pathway identification. Bioremediat J 10(4):179–190
Abdurruhman MA, Abdelbagi OA, Ahmed ASI (2015) Biodegradation of pendimethalin and atrazine by Pseudomonas pickettii isolated from pesticides polluted soil under laboratory conditions. J Biotechnol Sci Res 2(3):94–102
El Zorgani GA (1982) The status of DDT residues in Sudan. Progress report. Agricultural Research Corporation, Wad Medani, Sudan
Kole RK, Saha J, Pal S, Chaudhuri S, Chowdhury A (1994) Bacterial degradation of the herbicide pendimethalin and activity evaluation of its metabolites. Bull Environ Contam Toxicol 52:779–786
Thangadurai P, Suresh S (2014) Biodegradation of endosulfan by soil bacterial cultures. Int. Biodeterior. Biodegrad 94:38–49
Byeoung-Soo P, Sung-Eun L (2004) Biotransformation of endosulfan by Anabaena sp. PCC 7120. Agric Chem Biotechnol 47(1):38–41
Singh SB, Kulshrestha G (1991) Microbial degradation of pendimethalin. J. Environ Sci Health B26:309–321
Ulčnik A, Kralj CI, Pohleven F (2013) Degradation of lindane and endosulfan by fungi, fungal and bacterial laccases. World J Microbiol Biotechnol 29(12):2239–2247
Megadi VB, Tallur PN, Hoskeri RS, Mulla SI, Ninnekar HZ (2010) Biodegradation of pendimethalin by Bacillus circulans. Indian J Biotechnol 9:173–177
Okerentugba PO, Ezeronye OU (2003) Petroleum degrading potentials of single and mixed microbial cultures isolated from rivers and refinery effluent in Nigeria. Afr J Biotechnol 2(9):288–292
Elsaid OG, Abdelbagi AO, Elsheikh EAE (2011) Accelerating the rate of endosulfan degradation by bacteria and actinomycetes. Int J Appl Environ Sci 6(1):11–21
Singh PB, Sharma S, Saini HS, Chadha BS (2009) Biosurfactant production by Pseudomonas sp. and its role in aqueous phase partitioning and biodegradation of chlorpyrifos. Lett Appl Microbiol 49:378–383
Khaled AO, Gamal HI, Ahamed IA, Abdul Rahman AA (2008) Biodegradation kinetics of dicofol by selected microorganisms. J Pest Biochem Physiol 91:180–185
Rigas F, Papadopoulou K, Dritsa V (2007) Bioremediation of a soil contaminated by lindane utilizing the fungus Ganoderma austral via response surface methodology. J Hazard Mater 140(1–2):325–332
Awasthi N, Manikam N, Kumar A (1997) Biodegradation of endosulfan by a bacterial co-culture. Bull Environ Contam Toxicol 59:928–934
Jesitha K, Nimisha KM, Manjusha CM, Harikumar PS (2015) Biodegradation of endosulfan by Pseudomonas fluorescens. Environ Process 2(1):225–240
Kullman SW, Matsumura F (1996) Metabolic pathway utilised by phanerochete chrysosporium for degradation of the cyclodiene pesticide endosulfan. Appl Environ Microbiol 62:593–600
Katayama A, Matsumura F (1993) Degradation of Organochlorine pesticides particularly endosulfan by Trichoderma harzianum. Environ Toxicol Chem 12:1059–1065
Sutherland TD, Weir KM, Lacey MJ, Horne I, Russsel RJ, Oakeshott JG (2002) Enrichment of a microbial culture capable of degrading endosulphate, the toxic metabolite of endosulfan. J Appl Microbiol 92:541–548
Miles JRW, May P (1979) Degradation of Endosulfan and it is Metabolites by Mixed Culture of Soil Microorganisms. Bull Environ Contam Toxicol 23:13–16
Hai-yan N, Fei W, Na L, Li Y, Da Chen, Qin H, Jian H, Qing H (2016) The nitroreductase PNR is responsible for the initial step of pendimethalin degradation in Bacillus subtilis Y3. Appl Environ Microbiol. doi:10.1128/AEM.01771-16
Elsayed BB, El-Nady MF (2013) Bioremediation of pendimethalin-contaminated soil. Afr J Microbiol Res 7(21):2574–2588
Acknowledgments
The authors would like to thank Mr. Adam Ali Mohamed and Mr. Salah of the National Chemical Laboratories, Federal Ministry of Health, Sudan, for their help with GC–MS analysis. The financial support made available by the Ministry of Higher Education and Scientific Research, Sudan, is highly acknowledged. The Korean Macrogen Company and Kangwon National University (KNU) were greatly acknowledged for their help with the identification of bacterial isolates by Molecular Biotechnology tools.
Author information
Authors and Affiliations
Corresponding author
Electronic supplementary material
Below is the link to the electronic supplementary material.
Rights and permissions
About this article
Cite this article
Ishag, A.E.S.A., Abdelbagi, A.O., Hammad, A.M.A. et al. Biodegradation of endosulfan and pendimethalin by three strains of bacteria isolated from pesticides-polluted soils in the Sudan. Appl Biol Chem 60, 287–297 (2017). https://doi.org/10.1007/s13765-017-0281-0
Received:
Accepted:
Published:
Issue Date:
DOI: https://doi.org/10.1007/s13765-017-0281-0